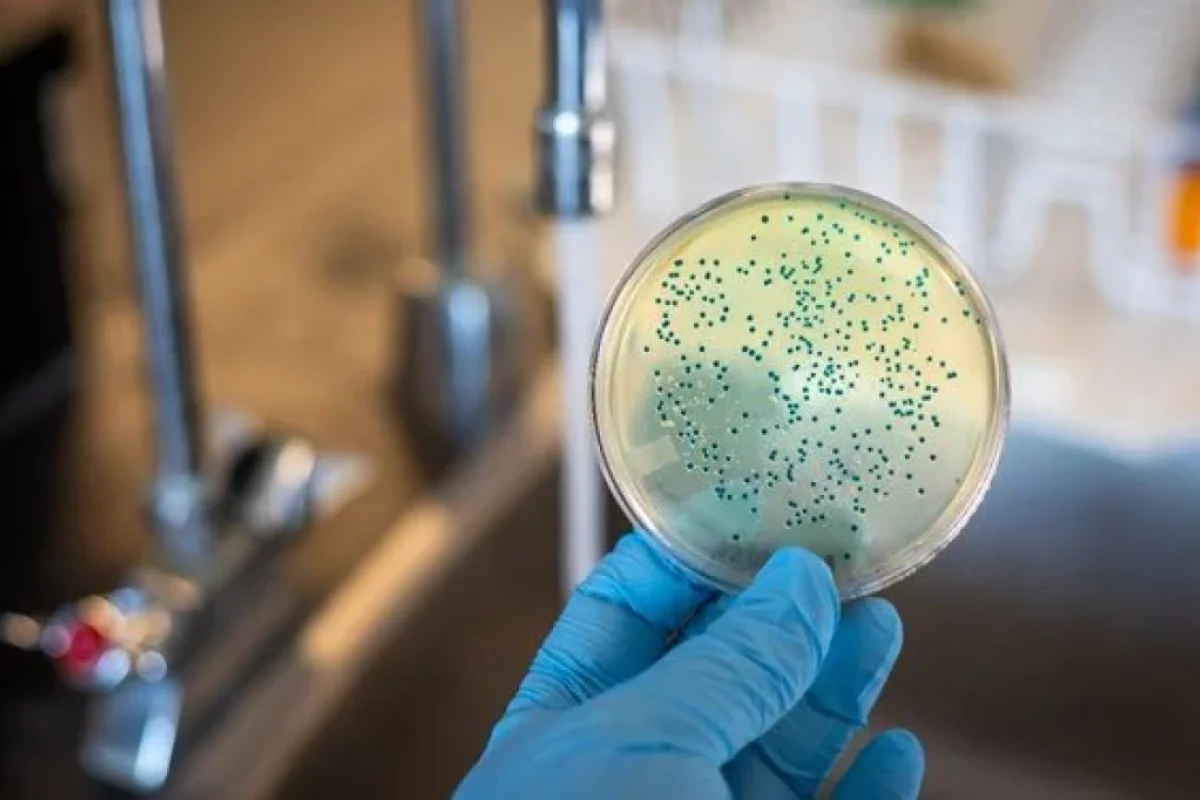

Yerə düşən yeməklərə diqqət edin
Sağlamlıq
Sağlamlıq
Alimlər yerə düşmüş qidaları yemək üçün təhlükəsiz vaxt haqqında yeni məlumatlar veriblər.
News24.az xəbər verir ki, bu, ilk növbədə yediyiniz yeməyin növündən və ikincisi, onu hara atdığınızdan asılıdır.
Qarpız parçaları, alma kimi "yaş" qidalar çips və ya peçenye kimi quru qidalardan daha tez daha çox bakteriya cəlb edir.
Bu il aparılan bir araşdırma göstərir ki, evinizdə bakteriyalardan qaçmaq üçün təhlükəsiz yer yoxdur.
Yeməkləri suyun altında saxlamaq toz və ya saç kimi bəzi görünən hissəcikləri təmizləsə də, yerdəki mikrobları yox etmir.
Food and Wine ilə danışan daxili xəstəliklər mütəxəssisi və qastroenteroloq Dr.Vendi "Təəssüf ki, beş saniyə qaydası mifdir" deyib.
Rutgers Universitetində 2016-cı ildə edilən bir araşdırma dörd növ qidanı araşdırdı: qarpız, çörək, yağlı çörək və saqqız.
Tapıntılar, beş saniyə qaydasından sonra ən çox bakteriyanın qarpızda (97 faiz), çörək və yağda isə müvafiq olaraq 94 və 82 faiz olduğunu ortaya qoyub.
Günel Məlikzadə




